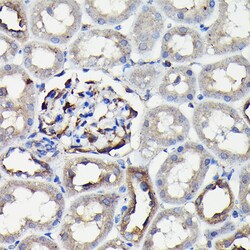

Learn More
Invitrogen™ MYH9 Polyclonal Antibody


Description
Positive test controls include: HeLa, HT-29, A-549, NIH/3T3, C6. The target is usually found in the following locations: Cytoplasm, cell cortex, cytoskeleton. Immunogen sequence: VKSKYKASIT ALEAKIAQLE EQLDNETKER QAACKQVRRT EKKLKDVLLQ VDDERRNAEQ YKDQADKAST RLKQLKRQLE EAEEEAQRAN ASRRKLQREL EDATETADAM NREVSSLKNK LRRGDLPFVV PRRMARKGAG DGSDEEVDGK ADGAEAKPAE.

Specifications
Specifications
| Antigen | MYH9 |
| Applications | ELISA, Immunohistochemistry (Paraffin), Western Blot, Immunocytochemistry |
| Classification | Polyclonal |
| Concentration | 0.79 mg/mL |
| Conjugate | Unconjugated |
| Formulation | PBS with 50% glycerol and 0.09% sodium azide; pH 7.3 |
| Gene | MYH9 |
| Gene Accession No. | P35579, Q62812, Q8VDD5 |
| Gene Alias | BDPLT6; Cellular myosin heavy chain, type A; DFNA17; epsts; fi22c04; fj85e11; flectin; Fltn; FTNS; KLG/PTK7; LOC100911597; LOW QUALITY PROTEIN: myosin-9; MGC104539; MHA; Myh9; myh9.L; myh9a; myh9l2; Myhn1; Myhn-1; myosin; Myosin Heavy Chain 2A; myosin heavy chain 9; myosin heavy chain IX; myosin heavy chain, non-muscle IIa; myosin IIA; myosin, heavy chain 9, non-muscle; myosin, heavy chain 9, non-muscle L homeolog; myosin, heavy chain 9, non-muscle, like-2; myosin, heavy chain 9a, non-muscle; myosin, heavy polypeptide 9, non-muscle; myosin, heavy polypeptide 9a, non-muscle; myosin-2a; myosin9; Myosin-9; myosin-9; myosin-9a; myosin-9-like; NMHC II-A; NMHC-II A; NMHCIIA; NMHC-II-A; NMMHC IIA; NMMHC II-a; nmmhca; NMMHC-A; NMMHC-IIA; non-muscle myosin heavy chain 9; non-muscle myosin heavy chain A; non-muscle myosin heavy chain II A; non-muscle myosin heavy chain IIa; nonmuscle myosin heavy chain II-A; non-muscle myosin heavy polypeptide 9; nonmuscle myosin II heavy chain A; TU72.6; Unknown (protein for IMAGE:7151033); Unknown (protein for IMAGE:7177375); Unknown (protein for IMAGE:7268224); wu:fi22c04; wu:fi22c04 protein; wu:fj85e11; XELAEV_18023533mg; zgc:162029; zgc:66164; zNMHC-IIA |
| Gene Symbols | MYH9 |
| Show More |
By clicking Submit, you acknowledge that you may be contacted by Fisher Scientific in regards to the feedback you have provided in this form. We will not share your information for any other purposes. All contact information provided shall also be maintained in accordance with our Privacy Policy.